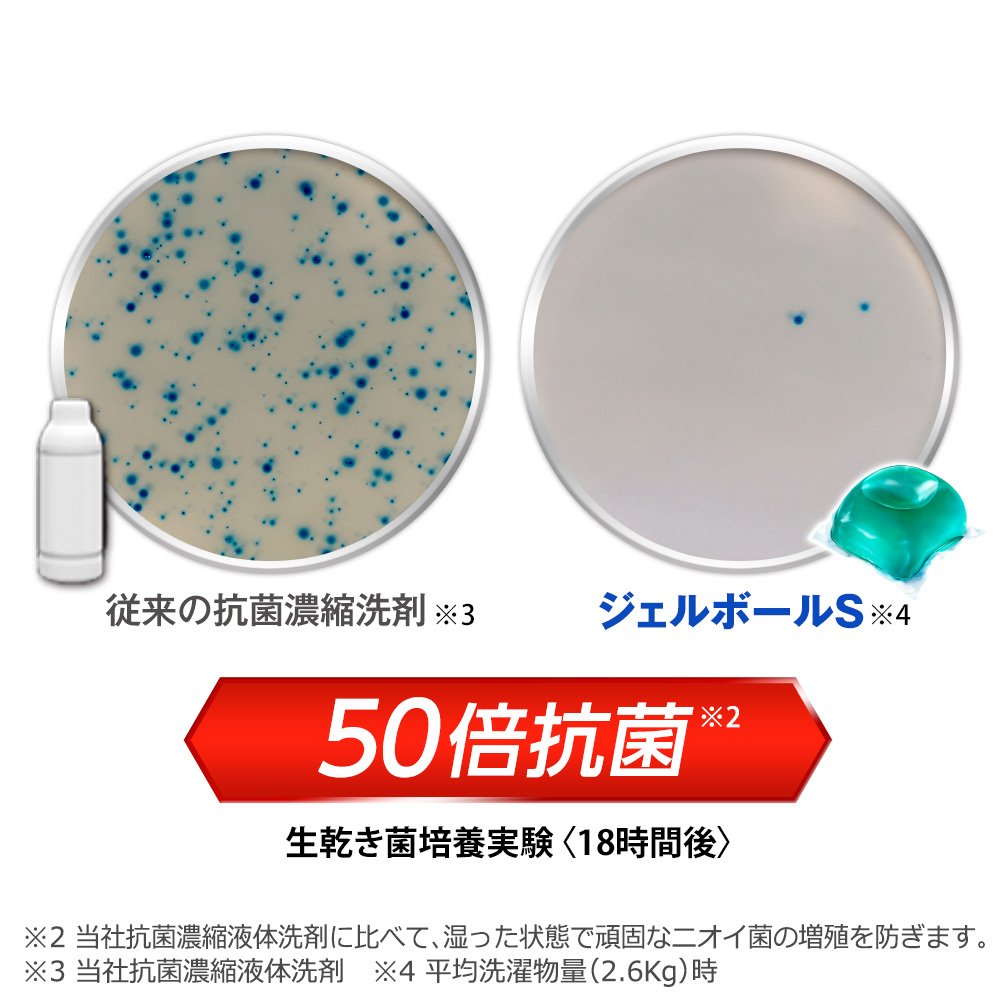

商品サイズ (幅×奥行×高さ) :210mm×180mm×300mm
原産国:日本
内容量:940g(48個入り)×2
商品紹介
通常の2倍* 超ジャンボサイズ。* *アリエールリビングドライジェルボールSつめかえ用(18個入り)対比 部分洗いなしでも、100種の汚れを一発洗浄*1 ジェルボールSは、一粒でコンパクト洗濯洗剤以上の強力な消臭洗浄力*2を発揮。 生乾き消臭の3つの効果を実現。毎日の部屋干しに最適。 50倍抗菌*3 従来の抗菌濃縮洗剤*4では抑えられなかった生乾菌まで抑えるアリエール独自のデュアルバイオ抗菌処方。 生乾き消臭 消臭カプセルで部屋干し特有のニオイまでしっかり消臭 ●計量いらずで一粒ポンと入れるだけ。 ●30L~65L(2.0kg~6.0kg)のお洗濯に適しています。 ●全自動洗濯機・ドラム式洗濯機 OK。 ●従来の液体洗剤つめかえ用とほぼ同じ回数使えます。*5 ●すすぎ1回OK。 ●クリーンフレッシュの香り ●洗濯槽のカビ防止*5 *1汚れの種類の詳細はWebで *2当社濃縮洗剤と比較。 消臭洗浄力とは消臭と皮脂汚れ洗浄の総合力を意味します *3当社抗菌濃縮洗剤に比べて。 *4当社抗菌濃縮洗剤 *5平均洗濯物量(2.6kg)縦型洗濯機使用 製品を安全にお使いいただくために 子供の手の届かないところに置いてください
使用上の注意
※子供に注意
※目に注意
※濡れた手で触らない
※切らない破らない
※洗剤投入口には入れない(製品がつまり、水があふれる恐れがあります。)
使用上の注意
●これは食べ物ではありません。
●子供やペットの手の届く所に置かない。
●口に入れたり、飲み込んだりしない。
●認知症の方などの誤飲を防ぐため、置き場所に注意する。
●用途以外に使わない。
●下洗いや手洗い用におすすめしません。
●製品を強く押したり、長時間触らない。
●製品が破れて原液が洗濯機のフタについたときは、水ですぐふき取る。
●小さくして捨てやすい、やわらかい素材を使用しています。開封前の破損や液漏れに注意してお取り扱いください。
●切り口や角で手を切らないようご注意ください。
● パッケージ裏面中央の小さな穴は外袋の膨張を防ぐための通気孔です。 製品およびパッケージの品質に問題はございませんので、ご安心ください。
応急処置
●万一飲み込んだ場合は、吐かせず、水を飲ませるなどの処置をして、医師に相談する。●目に入った場合は、こすらずにすぐ水で15分洗い流して、医師に相談する。●万一製品が皮膚や衣類に残った場合は、皮膚は水でよく洗い、衣類はぬるま湯にしばらくつけ置きしもみ洗いをしてください。